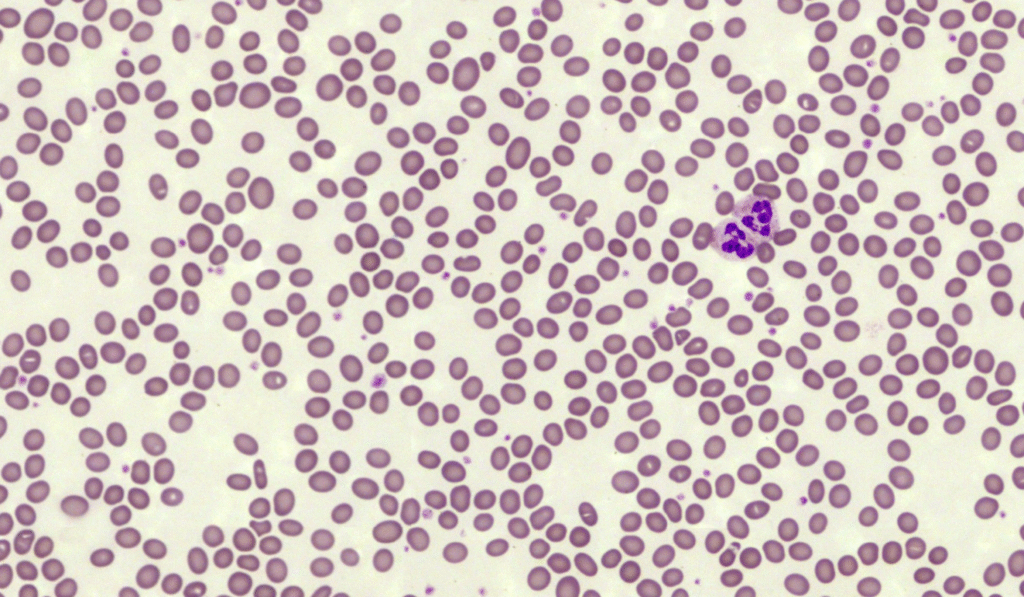

This week’s case comes from a patient of Southeast Asian descent who was recently admitted for a routine surgical workup. Interestingly, despite having no significant symptoms of anaemia, their laboratory results caught the attention of the haematology team.
Clinical context
The patient is originally from a malaria-endemic region. While they are clinically well and have a normal haemoglobin level, the automated analyser flagged several morphological warnings when processing the FBC.
Based on the blood film image and the clinical context provided:
- What abnormality are we seeing?
- What is the specific genetic mutation that causes this?
- What is the evolutionary advantage of this morphological trait?
As always, feel free to join in the comments below, or on Linkedin, or X.